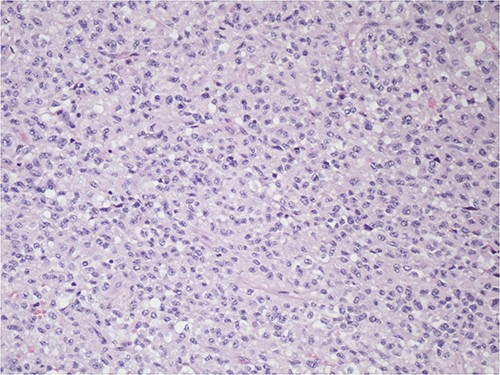

-
PDF
- Split View
-
Views
-
Cite
Cite
Olivia A Martin, Sabrina C Sopha, Cherif N Boutros, Not just a GIST: an unclassifiable neoplasm in the genomics era, Journal of Surgical Case Reports, Volume 2023, Issue 5, May 2023, rjad280, https://doi.org/10.1093/jscr/rjad280
- Share Icon Share
Abstract
Unclassifiable primary tumors despite adequate tissue for pathologic examination are quite rare. We present a case of a 72-year-old female who was found to have an abdominal mass after she reported to the emergency department with complaints of abdominal pain with spasms, bloating and nausea. Computed tomography scan demonstrated a 12.3 × 15.7 × 15.9 large multilobulated mass, abutting and compressing the stomach, compatible with neoplasm. She underwent esophagogastroduodenoscopy with findings concerning for gastrointestinal stromal tumor. The patient underwent en bloc resection of the mass. The neoplasm was unable to be classified on pathologic examination despite a comprehensive workup and multiple consultations with specialized pathologists from local institutions, as well as national specialists. Final pathology was unclassified malignant neoplasm displaying calretinin expression only. This presents a difficult clinical entity to treat. Even in the genomics era, there are tumors that cannot be even broadly classified on pathologic examination.
INTRODUCTION
While metastatic carcinoma of unknown primary tumor is relatively common (comprising 2–5% of all cancers diagnosed worldwide) [1–4], unclassifiable primary tumors despite adequate tissue for pathologic examination are quite rare.
CASE REPORT
The patient is a 72-year-old female who was found to have an abdominal mass on computed tomography (CT) scan after she reported to the emergency department with complaints of abdominal pain with spasms, bloating and nausea. She had no constipation or obstipation. Her past medical history was significant only for hypothyroidism, postconcussive syndrome with seizure and sleep apnea. She had no personal or family history of cancer. Her CT scan demonstrated a 12.3 × 15.7 × 15.9 large multi lobulated mass, abutting and compressing the stomach, compatible with neoplasm. Multiple smaller nodular masses were also identified along the omentum and mesentery. Her symptoms ultimately improved in the emergency department and she was discharged home. She underwent esophagogastroduodenoscopy and an 8 cm submucosal mass was identified at the greater curve, concerning for gastrointestinal stromal tumor. Biopsies showed only non-specific chronic inflammation, without metaplasia, dysplasia or malignancy. She was seen by medical oncology and CT-guided biopsy was performed and pathology was positive for neoplasm, favored granulosa cell tumor. Calretinin staining was positive. DOG1, CD34, CD68 and Melan A staining were all negative. CEA was 2.8. Chromogranin A was 82. Pre-operative physical exam found a large palpable abdominal mass in the left upper quadrant that crossed midline. The patient had discomfort with abdominal palpation and was distended.
After informed consent for surgery was obtained, the patient underwent en bloc resection of the abdominal mass with subtotal gastrectomy with roux-en-y reconstruction, transverse colectomy with colocolonic anastomosis and destruction of peritoneal nodules with an argon beam as fulguration of tumor implants with intra-operative liver ultrasound. On pathology the submucosal mass measured 18.0 × 14.2 × 11.4 cm with lymphovascular invasion. Five out of five lymph nodes were negative for tumor. Pathologic examination showed the tumor to be adherent to the colonic serosa and subserosa (Fig. 1). The tumor was composed of relatively monotonous cells with ample eosinophilic cytoplasm arranged in sheets. Nuclei show vesicular chromatin with prominent nucleoli and show a range of cytologic atypia. There was no characteristic vascular pattern (Fig. 2). On higher power, occasional mitotic figures were identifiable (Fig. 3).

The tumoral relationship with colonic muscularis propria, 20X H&E.
The tumor is composed of relatively monotonous cells with ample eosinophilic cytoplasm arranged in sheets; nuclei show vesicular chromatin with prominent nucleoli and also show a range of cytologic atypia; there is no characteristic vascular pattern, 100X, H&E.

Higher power of Fig. 2—one can occasionally find mitotic figures (center field), 400X, H&E.
The neoplasm was unable to be classified on pathologic examination despite a comprehensive workup and multiple consultations with specialized pathologists from local institutions, as well as national specialists. CD34, CD163, ERG, MDM2-ISH, BAP1, INI-1 and H3K27 were retained. No fusion transcripts were detected. Ultimately the final pathology was unclassified malignant neoplasm displaying calretinin expression only. There was absence of expression of keratins, other mesothelial markers or markers of steroid cell differentiation. Genomic testing revealed no actionable targets. Imaging 3 months after resection revealed peritoneal carcinomatosis. After discussion at the institution’s multidisciplinary tumor board, she is being treated for malignancy of unknown primary origin with carboplatin, paclitaxel and bevacizumab.
DISCUSSION
We present a case in which a very large tumor underwent en bloc resection and with adequate tissue for pathologic examination, the tumor cannot be classified. This presents a difficult clinical entity to treat. Even in the genomics era, there are tumors that cannot be even broadly classified on pathologic examination. We were unable to identify another such case in our literature review.
CONFLICT OF INTEREST STATEMENT
The authors have no conflicts of interest to report.